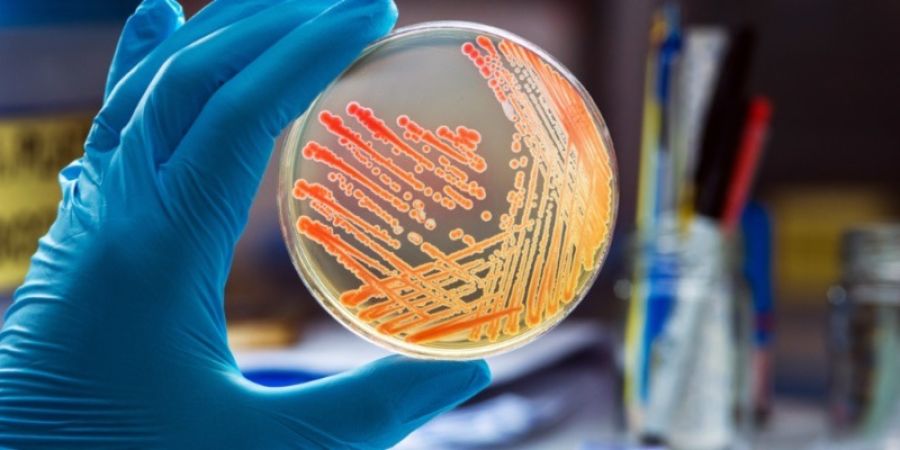
Bioburden, ¿análisis necesario en la industria manufacturera de dispositivos médicos?

Bioburden, ¿análisis necesario en la industria manufacturera de dispositivos médicos?
En primer lugar, el Bioburden o ensayo de carga biológica es utilizado con el fin de determinar la cantidad de bacterias que viven en una superficie no esterilizada; es decir, se emplea con el fin de identificar la población de microorganismos viables que se encuentran en un producto con una barrera estéril.
Importancia del ensayo de carga biológica
Este tipo de análisis es requerido en la industria manufacturera debido a que corresponde a uno de los últimos eslabones en el proceso de fabricación y ensamblaje de los dispositivos médicos. Por lo que, es necesaria una amplia capacidad de determinación y de cuantificación del Bioburden; esto a través de un proceso en el que se somete el producto no estéril por medio del cual “maximizará la oportunidad de recuperar los microorganismos presentes en el producto”. (Eurofins, 2022).
Por otro lado, es viable recalcar que, la posible carga biológica que se encuentre en este tipo de ensayos no depende solamente de ciertas incongruencias en el proceso de esterilización de los productos, sino que depende de factores tales como la “fabricación de componentes de la materia prima, procesos de montaje, entorno de fabricación, gases comprimidos, agua, lubricantes, los procesos de limpieza y de empaque del producto”. (Prieto, 2013, p.9).
Lo anterior significa que, el método empleado para realizar los ensayos microbiológicos debe de validarse a fin de garantizar: que se han considerado los tipos de microorganismos característicos de su posible contaminación (aerobios / anaerobios, mohos y levaduras, microorganismos específicos); y que se ha evaluado el factor de recuperación del método a la hora de cuantificar los microorganismos. (Eurofins, 2014).
Oferta de análisis
Como representantes de Eurofins en América Latina, contamos con la capacidad analítica de ofrecer diferentes métodos de última generación para la determinación y cuantificación de la carga biológica presente en sus productos y dispositivos.
Escríbenos a
Referencias bibliográficas
Eurofins BioPharma Product Testing. (2014). Control Microbiológico para productos sanitarios. Barcelona, España.
Eurofins Medical Device Testing. (11 de mayo de 2022). Bioburden Testing. Eurofins. Recuperado de https://www.eurofins.com/medical-device/services/microbiology-sterility/bioburden-testing/
Prieto, K. (2013). Evaluación del método microbiológico para la determinación de la población microbiana en tapones de goma para envase de productos farmacéuticos de acuerdo con la norma ISO 11737. [Trabajo de grado]. Pontificia Universidad Javeriana.